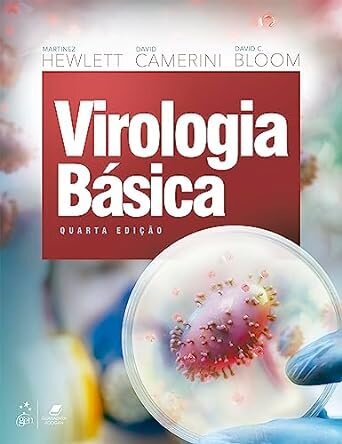
Virologia Básica

Virologia Básica
€ 106,00
Envio em 24 horas
Informação do Produto
| ISBN | 9788527739597 |
|---|---|
| Editora | Guanabara Koogan |
| Preço (iva excl.) | € 100,00 |
| Imposto | € 6,00 |
| Preço (iva inc.) | € 106,00 |
| Disponibilidade | 2 unidades em armazém externo |